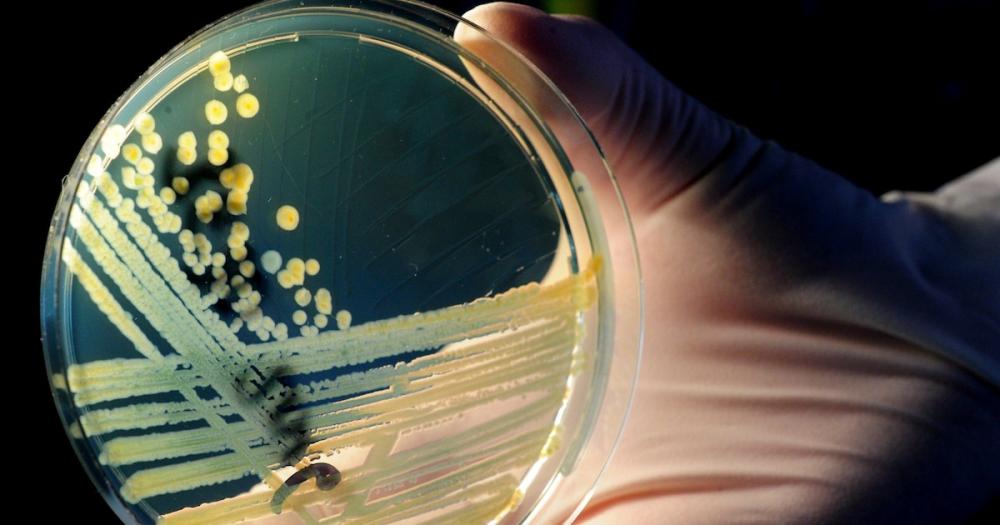

El Ejército israelí anunció la intercepción de un misil lanzado desde territorio yemení durante la madrugada de este jueves. Las sirenas de alerta por el cohete sonaron en las áreas de Mitzpe Ramon y Shitim en el sur del Néguev. Hasta el momento, ninguna organización terrorista se atribuyó la responsabilidad del ataque en el territorio liderado por el primer ministro Benjamín Netanyahu.El hecho ocurre un día después de que Israel intensificara su ofensiva contra los hutíes en Yemen. Las Fuerzas de Defensa israelís comunicaron a través de su canal de Telegram que, tras el sonido de sirenas en varias zonas del país, lograron interceptar el misil procedente de Yemen. Según las autoridades locales, no se reportaron víctimas fatales ni heridos.Cabe recordar que los rebeldes hutíes, respaldados por Irán, lanzaron repetidamente misiles y drones contra Israel. En medio del conflicto armado, el jefe del Estado Mayor de las Fuerzas, Eyal Zamir, ordenó el martes pasado una ofensiva contra Yemen. La misma tuvo un saldo de 35 muertos y 131 heridos.“El número total de víctimas ascendió a 166, entre ellas 35 muertas y 131 heridas”, afirmó el departamento hutí en un balance preliminar, mientras “los equipos de defensa civil, ambulancias y rescate continúan buscando a personas desaparecidas y mártires bajo los escombros”.Los drones israelíes en Saná, capital de Yemen, provocaron 28 muertos y 113 heridos, según informó el portavoz del Ministerio de Salud, Anees al Asbahi, en un comunicado recogido por agencias internacionales. Al Asbahi denunció que los bombardeos impactaron en “varias viviendas” del barrio de Al Tahrir, un “puesto médico” en el suroeste de la ciudad y un “complejo gubernamental” en Al Hazm, capital de la provincia de Al Jawf.El vocero expresó: “Declaramos nuestra firme e inequívoca condena al brutal crimen cometido por la entidad enemiga sionista, que lanzó varios ataques aéreos dirigidos directamente contra instalaciones civiles, de servicio y residenciales”.Por su parte, el Ejército israelí informó que bombardeó varias instalaciones vinculadas a las fuerzas armadas hutíes, entre ellas operaciones de prensa y un cuartel general de relaciones públicas militares. De acuerdo con un comunicado militar, los objetivos incluyeron campamentos militares donde se identificaron a operativos del régimen terrorista, así como una instalación de almacenamiento de combustible utilizada por el régimen terrorista.La tregua en crisisEl primer ministro de Qatar, jeque Mohammed bin Abdulrahman Al Thani, acusó a Benjamín Netanyahu de destruir la esperanza de los rehenes en Gaza tras el ataque israelí en Doha contra dirigentes de Hamas.Al Thani sostuvo que Qatar desempeñó el papel de intermediario clave en el conflicto de casi dos años y subrayó que la presencia de Hamas en Doha es pública. El primer ministro relató que se reunió con una de las familias de los rehenes la misma mañana en que Israel atacó a funcionarios de Hamas en el país, y remarcó: “Las familias cuentan con esta mediación (del alto el fuego). No tienen otra esperanza”.En referencia a la acusación de la Corte Penal Internacional contra el primer ministro israelí, Al Thani afirmó: “Debe ser llevado ante la justicia”. La crítica del jeque no se detuvo y fue por más: “He estado reconsiderando, incluso sobre todo el proceso durante las últimas semanas, que Netanyahu simplemente nos estaba haciendo perder el tiempo”.El premier israelí le recordó a Qatar y a todas las naciones que albergan terroristas que “o los expulsan o los llevan ante la Justicia, porque si no lo hacen, nosotros lo haremos”. En un video difundido por su Gobierno, Netanyahu cuestionó a la comunidad internacional y a su principal aliado: “Hicimos exactamente lo que hizo Estados Unidos cuando persiguió a los terroristas de Al Qaeda en Afganistán y, después, mataran a Osama bin Laden en Pakistán. Ahora, diversos países del mundo condenan a Israel. Deberían avergonzarse. ¿Qué hicieron después de que Estados Unidos eliminara a Bin Laden? ¿Dijeron ‘qué cosa tan terrible’? No, aplaudieron. Deberían aplaudir a Israel por defender los mismos principios”.(Con información de Europa Press y AFP)